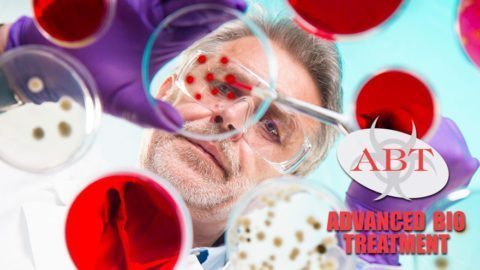

Murder Suicide Cleanup in Napa
Napa Valley Murder Suicide Cleanup It was a particularly quiet day today, and we haven’t seen much action here for a few days. We have been preparing for something outrageous because that’s usually how that works; the calm before the storm. We were all sitting in the office when we received the call that we needed to […]
Hayward, CA Homicide Cleanup
From Hayward, CA we received a call to our Northern California dispatch about a homicide cleanup. A phone call from a grieving mother who had just lost her son in a brutal homicide cleanup. Her son was murdered in his own home early in the morning the previous day. Apparently he was attempting to sell a […]
Halloween Hazards That Could Scare You to Death
Halloween Hazards Aside from the well-known and documented hazards of Halloween, like treats tainted with sharps and poison and pedestrians hit by cars, there are a few others that might never cross your mind. Glow Sticks Poison centers around the country get hundreds of calls around popular holidays like Halloween. The chemical that makes the […]
Mental Illness and Suicide: The Lethal Stigmas
September was National Suicide Prevention month. The goal of these designations is to raise awareness of a problem that is far more frequent and misunderstood than most of us realize. We at Advanced Bio Treatment realize it because so many of our calls involve cleaning up the scene of a suicide. They are some of […]
What You Don’t Know About Blood-Borne Pathogens
OSHA defines blood-borne pathogens as “infectious microorganisms in human blood that can cause disease in humans” (https://www.osha.gov/SLTC/bloodbornepathogens/). They include the deadly Hepatitis B and C viruses and also HIV. The Hepatitis B virus can live for up to a week on a contaminated surface. Hepatitis C can live for up to 4 days outside the […]
Hurricane Matthew: Hurricanes Are Not Just About Wind
Many of the communities we serve along the eastern coast, especially in our home state of Florida, were devastated by Hurricane Matthew last week. For those of you who have never experienced a direct or indirect hit by a powerful hurricane, count your blessings. Most people think that what makes a hurricane so dangerous is […]
Some Fun and Not-So-Fun Facts About Alcohol
It’s that time of year. The holidays are approaching. People celebrate more during this concentrated six-week period than they do throughout the entire rest of the year. They often have time off and attend a lot of parties and dinners. But people also experience some of the highest levels of stress and anxiety during the […]
Breast Cancer Awareness
Knowledge is Power… and It Just Might Save Your Life! October is breast cancer awareness month in which a national annual campaign attempts to increase awareness of this disease and help people put a plan in place for early detection, which is critical to recovery. The good news is that death rates from breast cancer […]
Deaths Among Palm Trees – Safety Precautions
In our South Florida service area, a typical landscape includes palm trees. And these seemingly innocuous trees can be deadly. Deaths among palm-tree trimmers result from things you might not suspect: suffocation, falling, crushing, and broken necks. Fronds on palm trees can weigh well over a hundred pounds each. When they are cut from the […]
Did You Know Drinking Too Much Water Can Kill You?
You hear it all the time: drink at least 8 glasses of water a day! Stay hydrated, especially if you work or play outdoors in the heat! Whole new niche markets have opened up selling take-along water bottles that allow you fill them yourself and easily measure the amount of water you drink each day. […]
Sleepwalking Mess: Hazardous Waste Cleanup
Sleepwalking Can Create Biohazardous Situations Somnambulism, or sleepwalking, is fairly uncommon, occurring in only about 7% of adults. According to the Mayo Clinic, sleepwalking occurs more often in children, and some research has shown that up to 17% of children may sleepwalk. Some evidence suggests that sleepwalking runs in families and that a person can be […]
Another Side to Death Behind the Macabre
Macabre – Five Unique Companies That Deal with Death Would Say “Absolutely!” Working in the business of death ourselves, we at Advanced Bio Treatment know that any death is complex and difficult. In an attempt to cope with the fear and mystery of death, cultural traditions that celebrate and honor death and the dead in […]
Typical Autumn Chores and Typical Serious Accidents
Typical Autumn Chores and Typical Serious Accidents Autumn is rapidly approaching and with it come the typical seasonal chores of cleaning gutters and roofs, especially in our more northerly communities that have a lot of deciduous trees. Our experience responding to and cleaning up accident sites has taught us that some seasonal chores should be […]
Who Cleans up After a Homicide?
Forensic Homicide Cleanup: Who Cleans up After a Homicide? Who cleans up after a homicide? Forensic cleanup companies remove biological hazards caused by homicides and workplace accidents. These specialists, called bioremediation specialists or forensic cleaners, follow specific guidelines to remove safety hazards and offer emotional support during a difficult time. Forensic cleanup specialists also serve […]
2016 Summer Safety Tips: Biohazard Cleanup
Don’t Let a Celebration End in the Emergency Room – or Worse 2016 Summer Safety Tips to Keep in Mind as Summer Comes to an End Biohazard cleanup is our life. It’s what we do. Because of what we see routinely in our jobs, we are big proponents of safety. That’s because we know that […]
The Zika Virus: What You Don’t Know Can Have Devastating Consequences
As summer winds down, deadly mosquitoes still thrive and multiply in places like Florida, where it stays hot all year in the southern part of the state and until December or January in the northern part. Don’t let the calendar or cooler temperatures make you complacent. Mosquitoes carry Zika, a serious infectious disease that causes […]
Advanced Bio Treatment Receives A+ Rating from Better Business Bureau
ABT awarded BBB accreditation Indicating the business has committed to meet certain principles of creating and maintaining trust August 29, 2016 – Advanced Bio Treatment is proud to announce it has met the accreditation standards required by the Better Business Bureau for membership with the organization. ABT knows that finding the right biohazard cleanup company can be […]
High Risk of Unattended Death: Summer Safety Tips to Prevent Hyperthermia
The blazing weather of summer brings special dangers to everyone who enjoys the outdoors, specifically the elderly, who run a risk of unattended death. However, high temperatures during heatwaves can even cause problems indoors when people fail to take the proper precautions. The elderly are especially at risk for hyperthermia in hot weather, because their […]
How to Discuss the Topic of Death with Your Children
How to Discuss Death with Children Death is a difficult subject especially when try to discuss death with children. It is an unavoidable part of life and it is inevitable that you will have to discuss death with your children at some point. Opening up the subject for discussion will help them when they are […]
After Suicide: The Role of Funeral Directors and Suicide Cleanup Services
Funeral Directors and Suicide Cleanup Suicide is often unexpected and the shock after suicide leaves those attached to the victim. They typically deal with a range of emotions, from feeling numb, angry, and even guilt. It undoubtedly has an impact on our nation. It’s considered a top major public health threat in the US, much […]
22 Push-Up Challenge: Saving the Lives of Veterans with Push-Ups
Last year, we had the Ice Bucket Challenge, sweeping across social media to become one of the most successful non-profit trends of the last decade. This year, there’s a new trend in town and it involves push-ups: 22 to be exact. The 22 Push-Up Challenge, lead by the global movement 22Kill, is on a mission […]
The Risk of Zika and MRSA To Athletes At The 2016 Rio Summer Olympics
On a cheery, bright afternoon, almost a decade ago, Brazilians flooded Copacabana Beach to celebrate the announcement from the International Olympic Committee that Rio de Janeiro would host the 2016 Summer Olympics. In the decade that Brazil has acquired the games, the country has become embroiled in all sorts of controversy– political turmoil, economic downturns, […]
Safety in the Workplace: The Importance of PPE Supplies
Ensuring safety in the workplace is a priority for every employer, but accidents do happen and the little details can make a big difference when it comes to protecting your employees. When dealing with a range of workplace accidents, from large-scale disease prevention like MRSA outbreaks, to microscopic bloodborne pathogens, it is important to stock personal […]
Unusual Commercial Death Cleanup: Burglar Found Dead in Chimney
People ask us all the time what the most unusual, strangest, or most comical death cleanup we have ever done and it gets us thinking about the variety of “shake-my-head” experiences we have had— things no one would believe could actually happen in real life. As dark as it sounds, we sometimes experience a bit […]
Accidental Death Scene Becomes Crime Scene Cleanup Mystery
In our business, the true details of a crime scene cleanup job don’t always match what is initially reported to us. The person making the call may be hysterical, grief-stricken, embarrassed, or misinformed about the crime scene. This often times results in the client giving us details that range from incomplete to completely inaccurate. What […]
The Complex, Hidden Dangers of Biohazard Cleanup
Biohazard cleanup is an extremely complex form of cleaning and restoration. Not only does it always involve some sort of traumatic, emotional event, it also poses a great risk for everyone involved– from the insurance adjuster, to the biohazard remediation company, and at last, the property owner that has been deeply affected by a tragedy. […]
Veteran Suicide Daily: Twenty-Two Too Many
Our veterans are in trouble– a lot of trouble. The veteran suicide rate is at an all-time high. According to K9s for Warriors, a veteran commits suicide almost every hour each day. On average, twenty-two veterans take their own lives every day because they cannot cope with what they have experienced in their military service, because […]
Bone Marrow Donation In High Demand: The Eliana Rose Story
Meet Eliana Rose Istre– the daughter of Melissa and USMC Gunnery Sgt Istre. Eliana was diagnosed with a rare form of Severe Congenital Neutropenia called Kostmann’s Syndrome, which directly hinders the production of neutrophils in bone marrow. Neutrophils are the tiny white blood cells that form an essential part of the immune system to fight […]
The Risks of DIY Blood Cleanup
All bodily fluids can carry blood-borne pathogens like bacteria, viruses, and fungi. This information comes straight from OSHA and the CDC. Additionally, because blood can be infected with deadly pathogens that cause HIV and Hepatitis, federal regulations consider all bodily fluids to be biohazards. Many people, however, want to cleanup blood themselves, in effort to save […]
Blood-Borne Pathogens: The Dangers of Blood and Bodily Fluids
Recently, an official from a Ronald McDonald House called us about an accident that occurred at the house and which involved copious amounts of blood. Prior to the call, volunteers at the house had cleaned up the accident scene, despite the major risk of blood-borne pathogens (BPP). After the fact, officials were concerned about the welfare […]
Wedding Plans End in Tragedy in Brevard, NC: Part 2
Read Part 1 Wedding Plans End in Tragedy in Brevard, NC: Part 2 An hour later, under the floodlights and windstorm of a search-and-rescue helicopter, Justin’s brutally murdered body was discovered in his parked car in the gravel lot off NC 151. A screaming, hysterical Anna Grace had leapt from Officer Kaminski’s vehicle and […]
Wedding Plans End in Tragedy in Brevard, NC: Part 1
Death Cleanup – Wedding Plans End in Tragedy in Brevard, NC: Part 1 Early Saturday morning, just as the sun rose, Justin decided to go for a run to get some exercise and, at the same time, recon the perfect spot to surprise his girlfriend of five years. It had to be perfect because he […]
Unattended Death in Wilmington, Delaware
Mysterious Terrible Odor Our highly trained technicians at Advanced Bio Treatment see a lot of interesting things in the field and often become an interwoven piece of the recovery story for the families and businesses involved. It’s just the nature of the industry, and it’s exactly why compassion and discretion are so essential. Discovering the […]
Elevator Malfunction Trauma Cleanup in Biloxi, Mississippi
Elevated Trauma Cleanup Derrek was terribly shaken when he made the call to Advanced Bio Treatment for emergency trauma cleanup services. Managing a mid-sized hotel in Biloxi, Mississippi had its ups and downs, but this was his first encounter with an accident of this magnitude. It was such a relief to talk to someone who […]
Forklift Injury at Work in Hendersonville, Tennessee
Trauma Cleanup – Warehouse Woes: Injury at Work According to OSHA, injury at work is 70% avoidable with proper training and safety guideline enforcement. When it comes to forklift use in the workplace, there are three common accidents that occur that are avoidable in most circumstances: forklift overturn, forklift striking or pinning a person, and workers […]
Glass Replacement Trauma Scene Cleanup in Alpharetta, Georgia
Last Spring, Advanced Bio Treatment was called out to a residence in Alpharetta, Georgia for a bloody trauma scene cleanup involving home glass installation. A glazier, who is a skilled tradesman who specialized in the cutting, removal, and replacement of residential and commercial windows and other glass fixtures such as sliding glass doors, auto glass, […]
Blood Cleanup Scene in Oakland, California Bathroom
Fast Food Filth It’s probably not surprising that some studies have found that 90% of children in the United States visit the largest fast food chain in the nation monthly, if not more. But when we add up the facts, it becomes more and more concerning. Study after study shows that a single patty of […]
Bloody Mess Cleanup at Pool in Lakewood, Ohio
Alcohol Plus Water = Trauma In the United States, about ten people each day die from drowning in non-boat related accidents according to the Center for Disease Control. Not surprisingly, in 2010 about 25% of drowning related emergency department visits involved the use of alcohol, and a whopping 70% of deaths related to water recreation involved […]
Raw Sewage for Breakfast in Springfield, Massachusetts
The Down and Dirty on Raw Sewage Anyone who’s had raw sewage back up into their home knows what a nightmare the repercussions are. The sheer expense alone is enough to make someone sick, not to mention the bacterial, viral, and parasitic concerns. According to the Environmental Protection Agency (EPA), over seven million people a […]
Accidental Death Trauma Cleanup in Pembroke Pines, Florida
Wood Chipper Trauma Cleanup Mitchell and Carlos had been with Mac Daddy Trees for over almost a year when the horrific Trauma Cleanup accident happened. Together with a crew of other workers, they’d taken a hundred large trees down on a plot of land in preparation for the development of a neighborhood in Pembroke Pines, Florida. They were working on grinding […]
Unattended Death Scene Cleanup in Burke, Virginia
Unattended Death Our technicians at Advanced Bio Treatment are highly trained in the field of crime scene cleanup, unattended death, and trauma cleanup, but we find that we learn something new every day and it’s often information that is life-saving. We’re eager to share our stories with you along with the invaluable lessons we pick […]
Dog-Sitting Gone Wrong: Trauma Cleanup in Jackson, Mississippi
Biting the Hand that Feeds You: Trauma Cleanup Angela and Steven Williams and their son Barrett lived in a close-knit neighborhood where neighbors were more like family than acquaintances. They celebrated birthdays and holidays together and had street parties on a regular basis whether for the 4th of July, the first day back to school, […]
Rochester Hospitals Unite to Defeat a Common Foe: C. Difficile
Wall Street Journal reports how health care providers are finding that when it comes to safety issues like infections, collaboration trumps completion. – C. Difficile A few years ago, in Rochester, NY, the main hospitals in the city, like many across the country, were struggling with rising rates of illness caused by a particularly ferocious […]
Thrill Park Trauma Cleanup in Atlantic City, New Jersey
Free Fall Amusement Turns to Terror With more than 400 amusement parks across the United States, it’s not surprising that Advanced Bio Treatment occasionally sends out a team of technicians to conduct a trauma cleanup involving blood cleanup or bodily fluid cleanup at a roller coaster thrill park or a water park. Most amusement park situations […]
Black Bear Attack Leads to Biohazard Cleanup in Orlando, Florida
Unprovoked Wildlife Attack It was late in the morning and Jean was trying to get her children to go outside and play. She wanted to clean up the house and get some chores done and it was beautiful outside. Her home is situated on a beautiful lot that backs up to vast natural preserve, wooded […]
Escalator Entanglement Trauma Cleanup in New Jersey
A Crushing Experience Leads to Trauma Cleanup It was the end of a big game as fans flooded the stairs and escalators leading down to the parking decks and lots. Overloaded with rowdy college students, young families with sleepy little ones, and old timers holding the railing to keep balance, the escalator suddenly halted and […]
Gun Play Gone Wrong in Charleston, South Carolina
Blood Cleanup: Scared to Death, Literally Our technicians at Advanced Bio Treatment will tell you that they see all kinds of tragedy related trauma, but that it’s the avoidable accidents that are hardest to cope with. The careless, negligent mistakes that are the most haunting, like toying with guns, letting children play unattended in or […]
Mile-High Miracle: Destination San Francisco, California
Some Trauma Cleanup’s are Worth all the Mess At Advanced Bio Treatment, we encounter some incredible situations often with outlandish stories. The sheer nature of our business lends itself very often to tragedy, but occasionally we get the opportunity to be part of someone’s greatest moment or a close call that ends in relief and […]
Food Plant Accident Scene Cleanup in Reno, Nevada
Avoid the Daily Grind – biohazard cleanup Advanced Bio Treatment is honored to serve cities all over the United States to perform biohazard cleanup. Our team of highly trained staff and technicians are equipped to assess every situation to ensure that the unique circumstances of the tragedy that has occurred are addressed and remediated. In […]
Crime Scene Cleanup in Baltimore, Maryland
A Bad Start – Crime Scene Cleanup It was a snowy, wet Baltimore Monday morning as Teresa pleaded with her car to crank, already running late to her first appointment. It was one of those days that you just have to take a deep breath and know all will work out, she remembers. She never thought […]